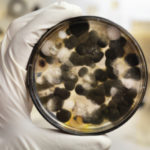

As a general rule, try to minimize any long gaps during the day without fuel, Sheth says, noting that 5 to 6 hours between meals is the absolute max most people with diabetes should push it. Some people may even need to eat every 3 to 4 hours for optimal blood sugar management, adds Phelps.
Furthermore, What should I eat if my sugar is high?
Here are seven foods that Powers says can help keep your blood sugar in check and make you happy and healthy to boot.
- Raw, Cooked, or Roasted Vegetables. These add color, flavor, and texture to a meal. …
- Greens. …
- Flavorful, Low-calorie Drinks. …
- Melon or Berries. …
- Whole-grain, Higher-fiber Foods. …
- A Little Fat. …
- Protein.
Additionally, What is the 500 rule in diabetes?
Use the 500 Rule to estimate insulin-to-carb ratio: 500/TDD = number of carb grams covered by a unit of insulin. Example: 500/50=10; 1unit of insulin will cover about 10 grams of carbohydrate.
Also What is the best thing for a diabetes to eat before bed?
To combat the dawn phenomenon, eat a high-fiber, low-fat snack before bed. Whole-wheat crackers with cheese or an apple with peanut butter are two good choices. These foods will keep your blood sugar steady and prevent your liver from releasing too much glucose.
Simply so, What can a diabetes eat at night?
Try one the following healthful snacks before bed to help manage blood sugar levels and satisfy nighttime hunger:
- A handful of nuts. …
- A hard-boiled egg. …
- Low-fat cheese and whole-wheat crackers. …
- Baby carrots, cherry tomatoes, or cucumber slices. …
- Celery sticks with hummus. …
- Air-popped popcorn. …
- Roasted chickpeas.
How can I bring my blood sugar down ASAP?
The following tips can help:
- Eat a consistent diet. …
- Get consistent exercise. …
- Reduce stress. …
- Stay hydrated. …
- Get a good night’s rest. …
- See your doctor. …
- Maintain a healthy weight. …
- Stick to your medication and insulin regimen.
Contenus
22 Related Questions and Answers Found
What snacks are good for high blood sugar?
Snacks to Help Stabilize Your Blood Sugar
- Apples and nut butter. Apples with the skin left on are a good source of fiber. …
- Tuna fish and whole-grain crackers. Canned tuna is an inexpensive way to get in a dose of protein with the added benefits of omega-3 fatty acids. …
- Homemade energy bars.
How do diabetics feel when their sugar is high?
The main symptoms of hyperglycemia are increased thirst and a frequent need to urinate. Other symptoms that can occur with high blood sugar are: Headaches. Tiredness.
What is the 450 rule in diabetes?
The 500 Rule (aka 450 Rule) from Using Insulin and the Pocket Pancreas is a great way to estimate how many grams of carbohydrate will be covered by one unit of Humalog or Novolog insulin. This is your insulin to carb ratio or your carb factor.
How bad is 400 blood sugar?
The Danger of Blood Sugar Readings in the 400’s
Over 400 is considered extremely high. There’s no such thing as “400 is as bad as 250.” A glucose reading of 400 means there’s a heck of a lot of sugar in the bloodstream.
How much does 1 unit of insulin bring down blood sugar?
One unit of insulin should cause your blood sugar level to drop 30 to 50 mg per dL, but you may need more insulin to get the same effect.
What kind of chips can diabetics eat?
Best chips for diabetes
- Beanitos chips.
- Hippeas White Cheddar Chickpea Puffs.
- Food Should Taste Good Tortilla Chips.
- Late July Organic Chia & Quinoa Tortilla Chips.
- Beanfields Chips.
Are bananas good for diabetics?
Bananas are a safe and nutritious fruit for people with diabetes to eat in moderation as part of a balanced, individualized diet plan. A person with diabetes should include fresh, plant food options in the diet, such as fruits and vegetables. Bananas provide plenty of nutrition without adding many calories.
Do diabetics wake up hungry?
Diabetes causes trouble regulating blood sugar levels. In type 2 diabetes, for example, cells don’t respond to insulin and sugar circulates in the blood. The result is that your body never gets the energy it needs, so you continue to feel hungry.
What time should diabetics stop eating at night?
Some experts say not eating for two hours before going to bed helps prevent high blood sugar (glucose) levels and related health problems such as diabetes and heart disease.
What foods lower blood sugar immediately?
Some of the foods that help keep your blood sugar levels in the healthy range include:
- Vegetables: Green peas. Onions. Lettuce. …
- Certain fruits: Apples. Pears. Plum. …
- Whole or minimally processed grains: Barley. Whole wheat. Oat bran and rice bran cereals. …
- Dairy and dairy-substitute products: Plain yogurt. Cheese. Cottage cheese.
How can I lower my blood sugar overnight?
For Somogyi effect:
- Decreasing the dose of diabetes medications that are causing overnight lows.
- Adding a bedtime snack that includes carbs.
- Doing evening exercise earlier.
- If you take insulin, switching to an insulin pump and programming it to release less insulin overnight.
Do lemons lower blood sugar?
Lemons also have a low glycemic index (GI), and a meal with a low GI promotes lower blood sugar and insulin levels after eating. Citrus fruits like lemons also contain flavonoids, naringin, and naringenin – all of which can have anti-inflammatory, antioxidant effects, according to a 2014 study in Advances in Nutrition.
Is cheese bad for a diabetic?
People with diabetes can safely eat cheese as part of a balanced, healthful diet. As with other foods, moderation is key, and so a diet that includes too much cheese would be harmful to people with or without diabetes.
Can you eat popcorn if your sugar is high?
Due to its relatively low-calorie and high-fiber content, air-popped popcorn can be a good option for people with diabetes too. However, people with diabetes need to take other factors into account when selecting snacks.
At what sugar level is diabetic coma?
A diabetic coma could happen when your blood sugar gets too high — 600 milligrams per deciliter (mg/dL) or more — causing you to become very dehydrated. It usually affects people with type 2 diabetes that isn’t well-controlled.
What fruits should a diabetic avoid?
However, fruit can also be high in sugar. People with diabetes must keep a watchful eye on their sugar intake to avoid blood sugar spikes.
…
Fruits high in sugar
- watermelons.
- dried dates.
- pineapples.
- overly ripe bananas.
What is a good breakfast for prediabetes?
A healthy prediabetes breakfast can stabilize blood sugar and improve insulin action for hours, and it need not take hours to prepare.
…
- Greek-Style Scrambled Eggs. …
- Overnight Spiced Peanut Butter Oatmeal. …
- Superfoods Breakfast Bowl. …
- Cereal and Yogurt. …
- Cottage Cheese Roll-Up.
Editors. 26 – Last Updated. 26 days ago – Users. 9